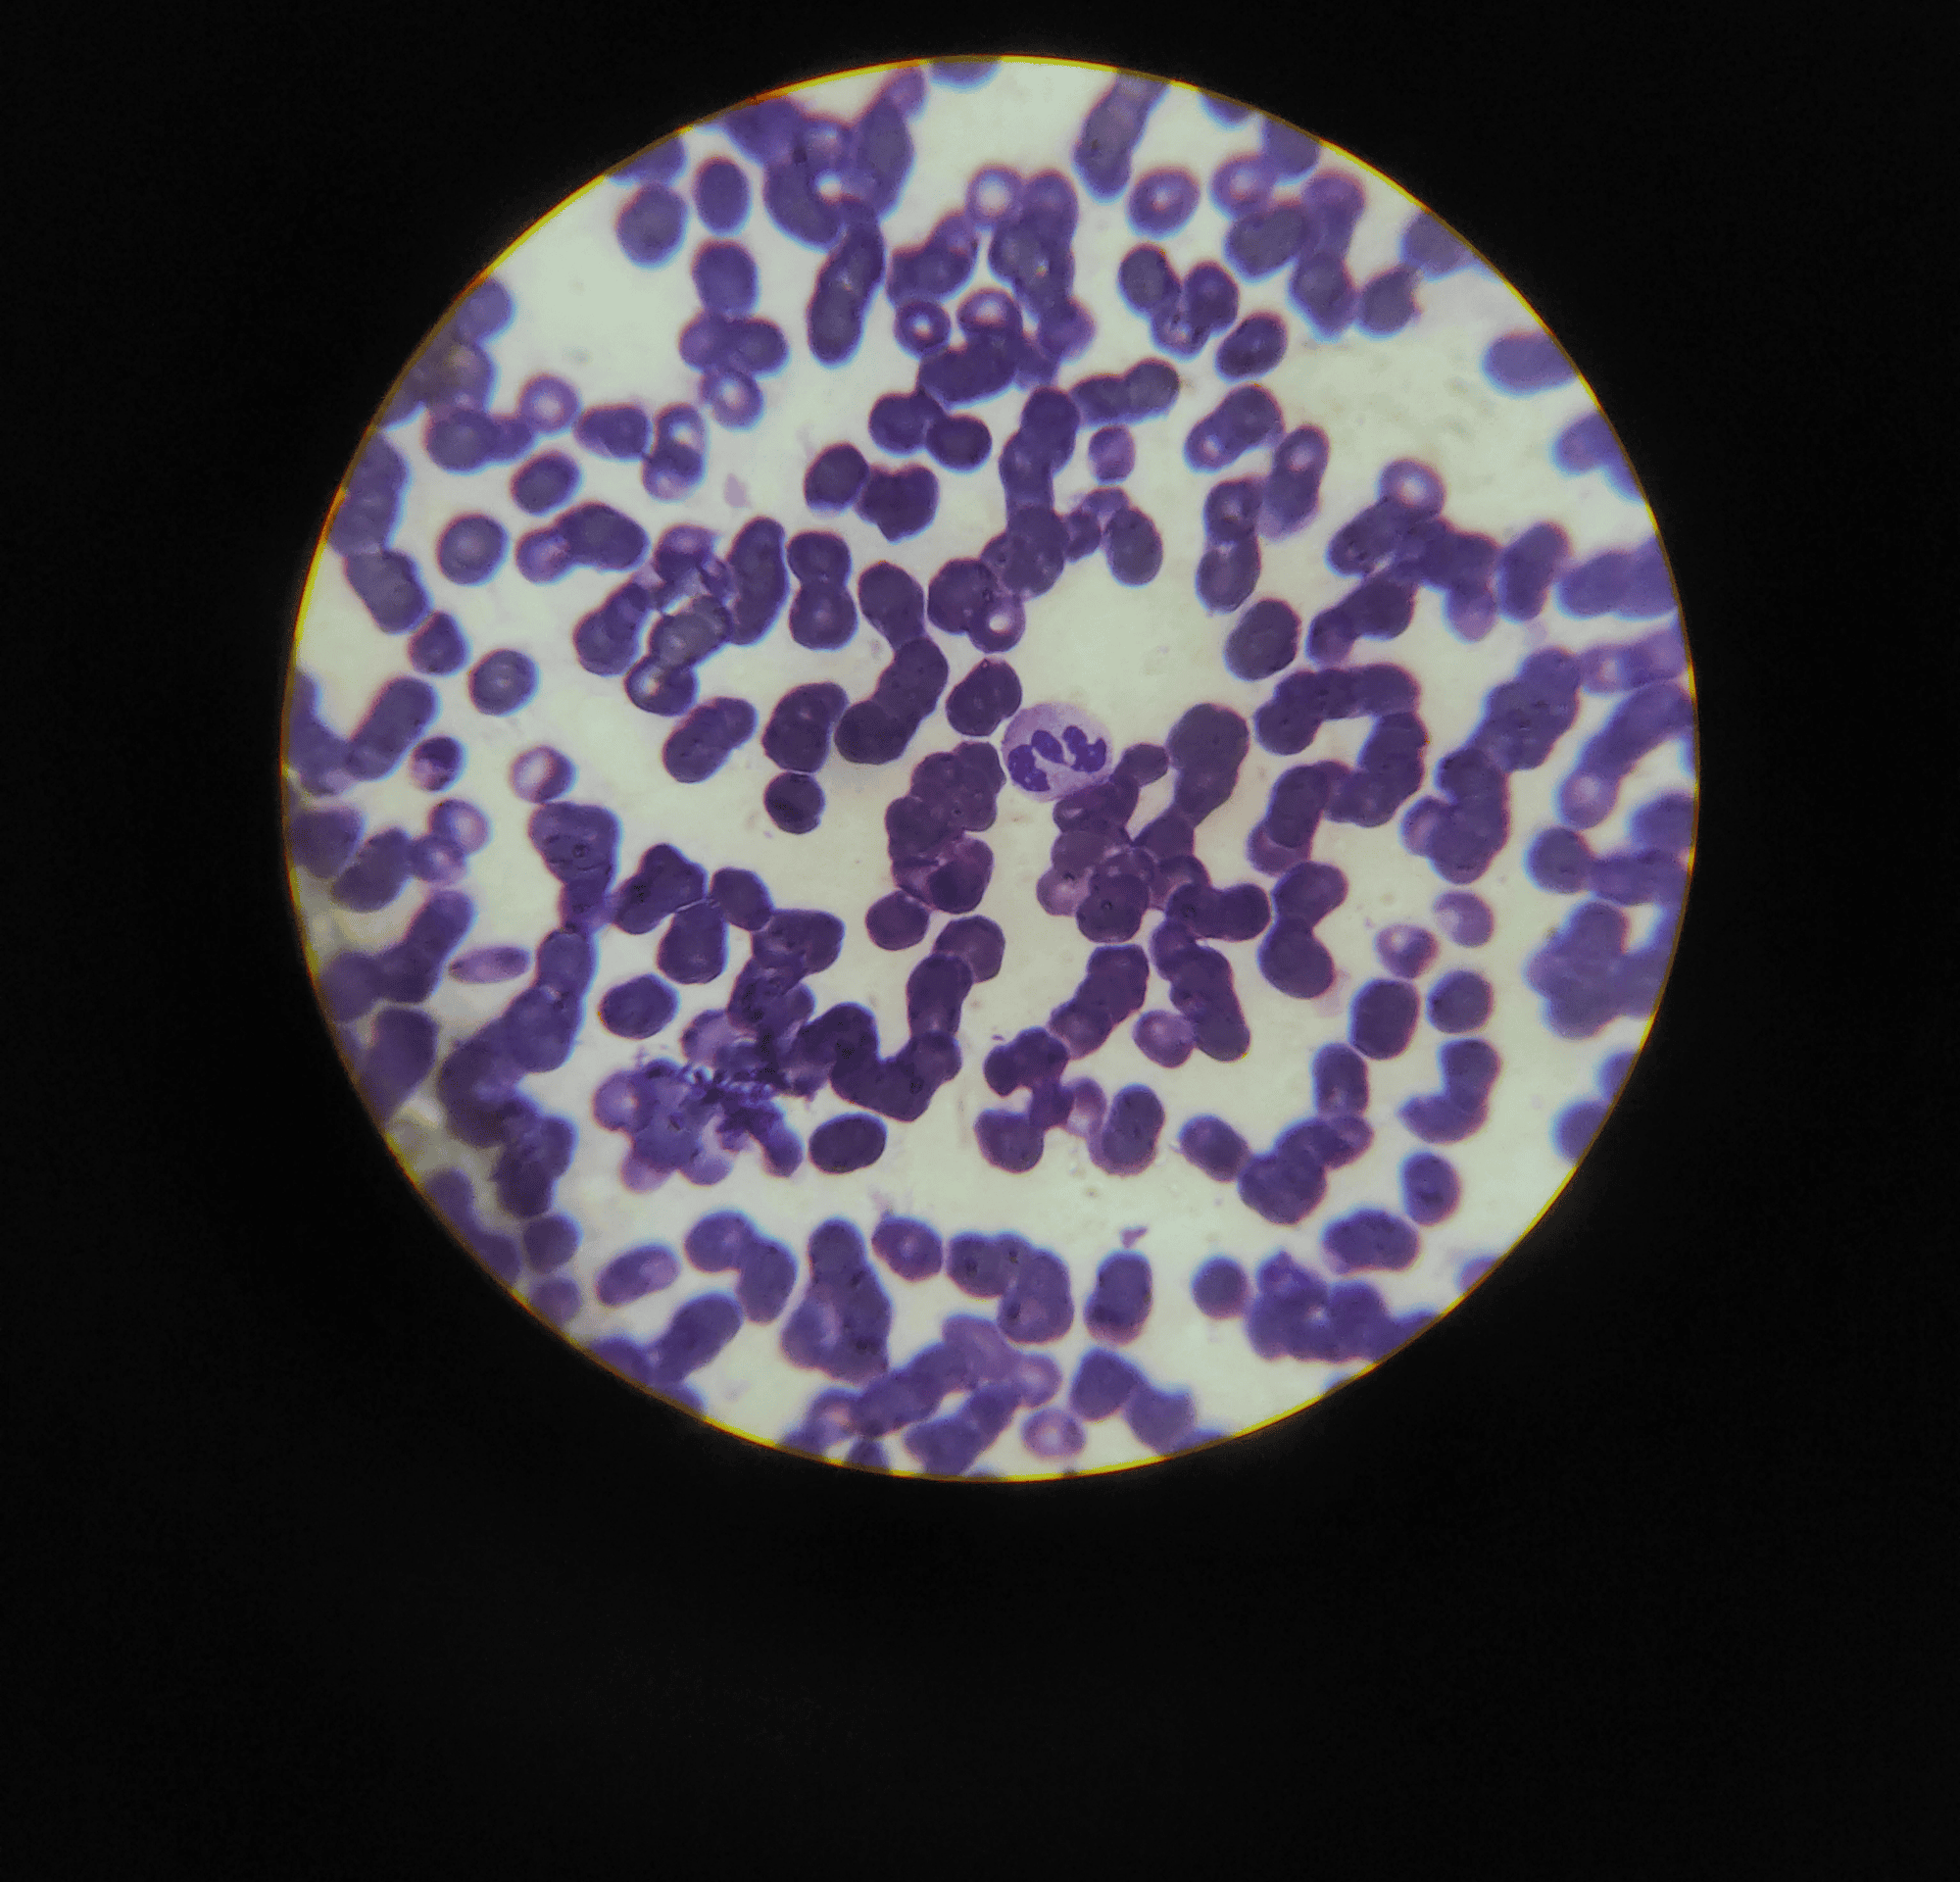

INSIGHTS | 5 min read
Cytology Testing: Uses in Cancer Detection & Diagnosis
Dr. Vrundali KannothWednesday 15th AprLearn More
INSIGHTS | 5 min read
Paget's Disease of the Breast: Signs & Treatment Guide
Dr. Sunny GargWednesday 15th AprLearn More
INSIGHTS | 5 min read
Dysplasia: Early Signs, Causes, and Treatment Options
Dr. Vrundali KannothWednesday 15th AprLearn More
INSIGHTS | 5 min read
Cancer Phobia (Carcinophobia): Understanding Causes, Symptoms, and How To Cope
Dr. Vrundali KannothWednesday 15th AprLearn More
INSIGHTS | 5 min read
Living With Chronic Cancer: Understanding Manageable Long-Term Cancer Conditions
Dr. Vrundali KannothWednesday 15th AprLearn More
INSIGHTS | 5 min read


